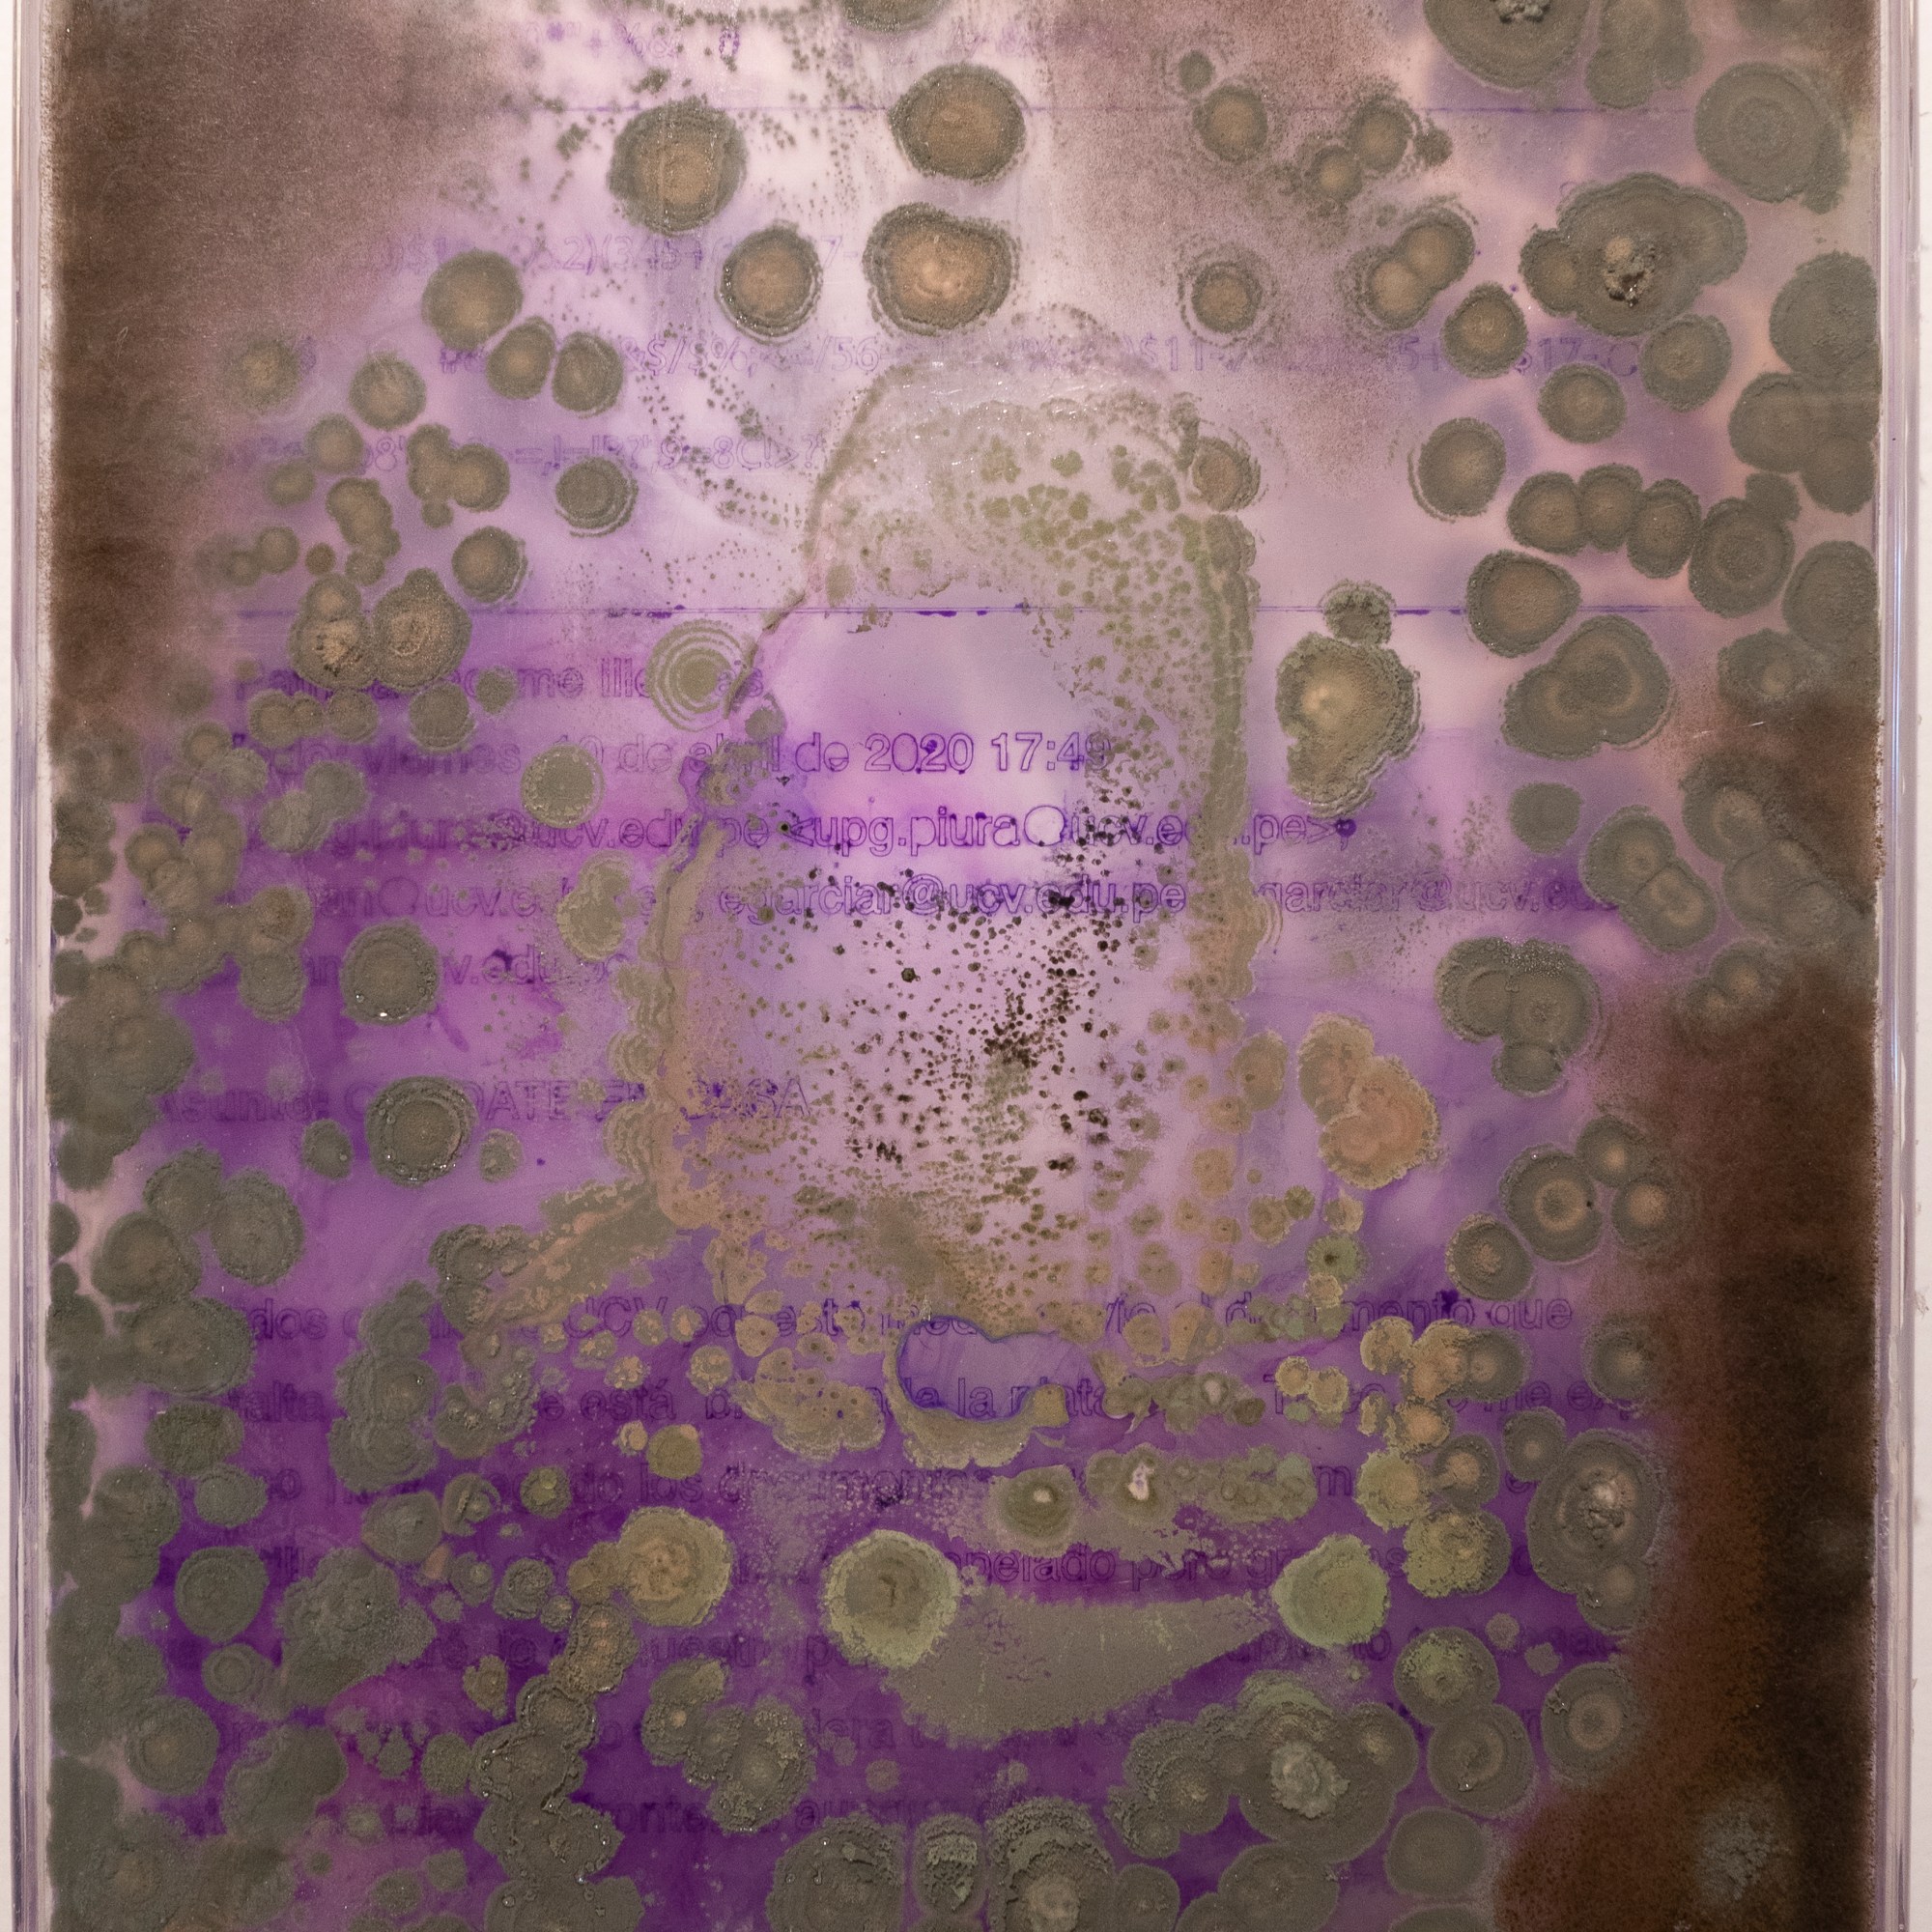

Colonizar el fin [Kallumpakunamikan shunku / Kuyllur]
Los hongos están al final de la cadena de la vida, pero también al principio y en este proyecto son parte de un ritual-visual de sanación, cambio y cierre que buscan transformar la experiencia personal del artista ante la muerte de su madre, en un rito socializado, un homenaje o una caja funeraria espacial. Las obras parten de la apropiación del conocimiento científico y utiliza la micología y la astronomía para presentar un proyecto expositivo que busca activar una sanación simbólica.
Kallumpakunamikan shunku (hongos y corazón) es la pieza principal de este proyecto para la cual se crearon dispositivos de materialización de información en formas de cajas petri que visualizan correos electrónicos sin enviar, sin contestar, mensajes en redes sociales o notas manuscritas que reflejan el momento previo a la muerte de la madre del artista. La información fue transferida con materiales antisépticos como la violeta de genciana, merthiolate rojo y yodopovidona. Estas cajas de información fueron inoculadas con diferentes géneros de hongos Penicillium y Rhizopus que a nivel simbólico sirven como materia viva de curación que transforma la Información, la borran y dan cierre a un ciclo.
Materiales:
Kallumpakunamikan shunku. Hongos Penicillium, Rhizopus y levaduras, cajas petri de metacrilato con cartas transferidas con violeta de genciana, merthiolate y yodo, vara de cobre.
Kuyllur. Resina poliéster cristal, luces led y video digital.
Exhibición: Teoría de la generación espontánea
SOMA 2021